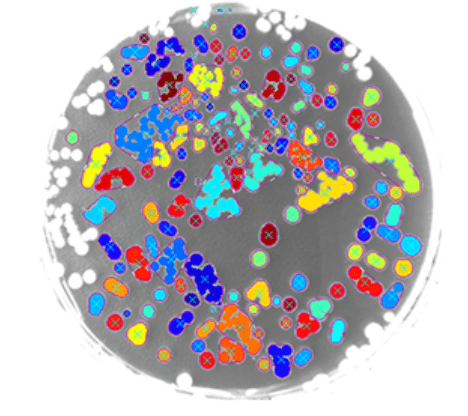

Easy Object
Blob analysis library

Main > Product > Image Processing Software > Euresys eVision > Open eVision Libraries > Easy 3D object

Easy Object
The EasyObject library handles image segmentation, i.e. the decomposition of images into separate objects, also called blobs. Once the objects have been constructed, they can be handled as independent entities. Various geometric parameters or features, such as area, width, or ellipse of inertia, can be computed for each object. Objects of interest can be selected by means of their position or of their computed features. EasyObject also supports the inspection of holes in defined objects. Holes are managed as the objects themselves, benefiting from the same geometrical features. EasyObject manages the relationship between objects and holes, defining parent objects for holes.
The Highlight Features
- Image segmentation based on the gray scale of connected objects
- Object labeling
- Geometric feature extraction
- Flexible Masks
- High performance, especially for large images and images with numerous objects
Key Features

Neo Licensing System

EasyImage can also generate Flexible Masks from an encoded image.
Object/Blob Features

- Position: Limit (top, bottom, left, right), Gravity center (X and Y), Weighted gravity center (X and Y)
- Extent: Area (pixel count), Feret box (center X and Y, height, width with distinct orientation angles at 22, 45, 68 degrees), Bounding box (center X and Y, height, width), Minimum enclosing rectangle (angle, center X and Y, height, width)
- Starting point of the object contour (X and Y)
- Longest run
- Run count
- Object number (index)
- Statistics: Pixel gray-level value (average, deviation, variance, min and max)
- Ellipse of Inertia: Eccentricity of the ellipse of inertia, Ellipse, Second order geometric moments
- Convex hull
The objects can be drawn onto the source image. The following blob features have a pre-set graphical representation : Objects , Diagonals , Bounding box , Convex hull , Ellipse, Feret Box, Feret box with an angle of 22°, Feret box with an angle of 45°, Feret box with an angle of 68°, Gravity center, Minimum enclosing rectangle, Weighted gravity center.
Extra Note
- All Open eVision libraries are available for Windows and Linux
Vital Vision provides a wide range of machine vision products. There is more than 2000 products for your different machine vision solution.
To know more details, please direct to our sales person today !



